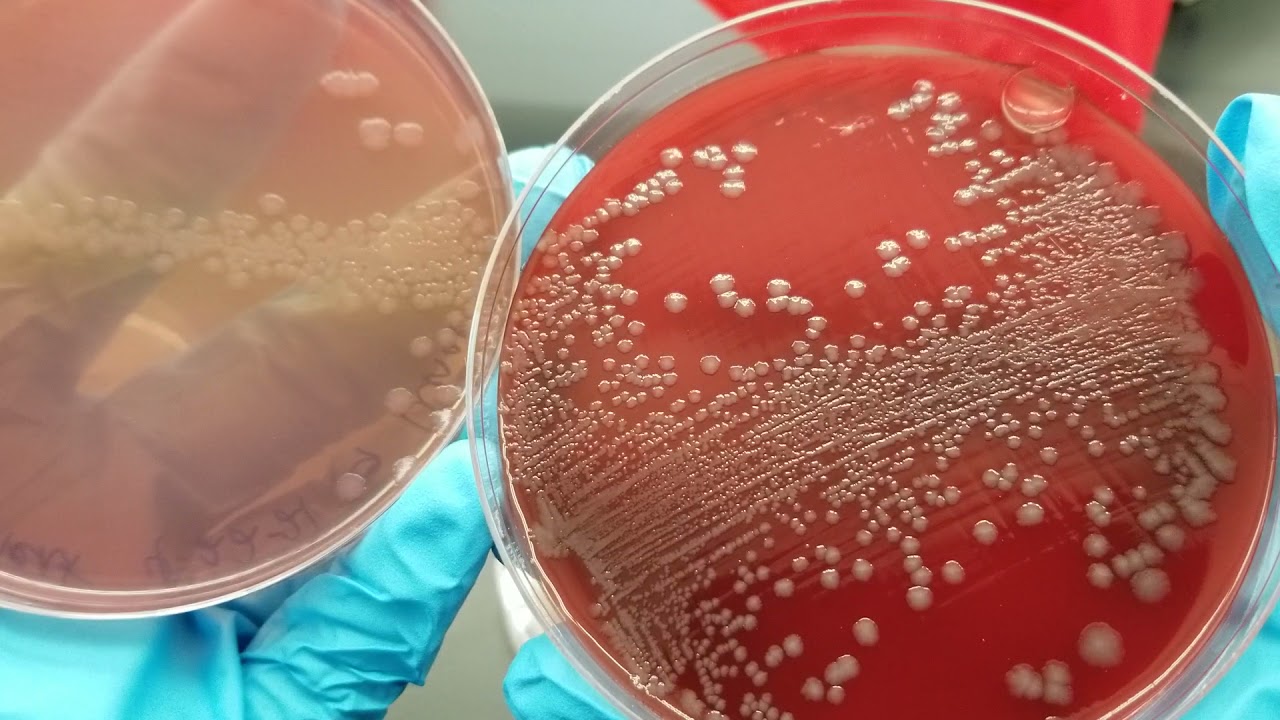
Microbiology Urine Culture Primary Set Up Inoculation And Colony Count Microbiology Urine Culture Primary Set Up Inoculation And Colony Count

How To Read Urine Culture Test Report Apr 4 2024 0183 32 chunsiong zoom i am using GitHub zoom meetingsdk win raw recording sample A patch of the Zoom Meeting SDK for Windows that enables raw recording
Jul 25 2025 0183 32 The Zoom Apps SDK empowers developers to build apps that run in Zoom enabling engaging experiences during and outside of a Zoom meeting May 12 2025 0183 32 Hello we currently have custom website variables that are being passed from our internal website to Zoom contact center Some of these variables include the phone number
How To Read Urine Culture Test Report
How To Read Urine Culture Test Report
https://i.ytimg.com/vi/CsYMJjSNYFw/maxresdefault.jpg
Community forum for Zoom s APIs SDKs and developer tools
Templates are pre-designed files or files that can be used for numerous functions. They can save effort and time by providing a ready-made format and design for developing various sort of material. Templates can be used for personal or professional jobs, such as resumes, invites, flyers, newsletters, reports, presentations, and more.
How To Read Urine Culture Test Report

SheilahHammad
UTI Lab Test Panel Painful Urination Urine Test Accesa Labs 54 OFF

Interpreting A Urine Culture Sensitivity YouTube

Get A Urinalysis Test Near You Order A Urine Analysis Test Online

Complete Analysis Urine Report

Urine Culture Introduction Importance Sample Collection Test Procedure

https://devforum.zoom.us › issue-with-downloading-meeting-recording-tr…
Jul 10 2025 0183 32 This flag ensures the Authorization header is passed along when following the redirect which resolves the issue with downloading files from Zoom Your explanation led me

https://devforum.zoom.us › zoom-account-id-client-id-client-secret
Apr 23 2024 0183 32 I m trying to add zoom to a 3rd party provisioning tool and it needs the Connection Name Account ID Client ID and Client Secret I ve been searching for this in both my zoom

https://devforum.zoom.us › join-meeting-error-after-host-ends-the-session
Dec 10 2024 0183 32 Description When the host ends the meeting client leave true and the guest attempts to join the room simultaneously calling client join meetingId token userName

https://devforum.zoom.us › zoom-is-not-running-at-all
Jan 11 2024 0183 32 Thank you for your post in the Zoom Developer Forum Just to clarify the Zoom Developer Forum is primarily used for discussions related to developer related questions about
https://devforum.zoom.us › meeting-join-token-not-working-in-zoom-me…
Feb 21 2025 0183 32 I am building a zoom bot using meeting zoom linux sdk I am using clone of zoom linux sdk example for my setup I am now trying to add my bot to a meeting which requires
[desc-11] [desc-12]
[desc-13]